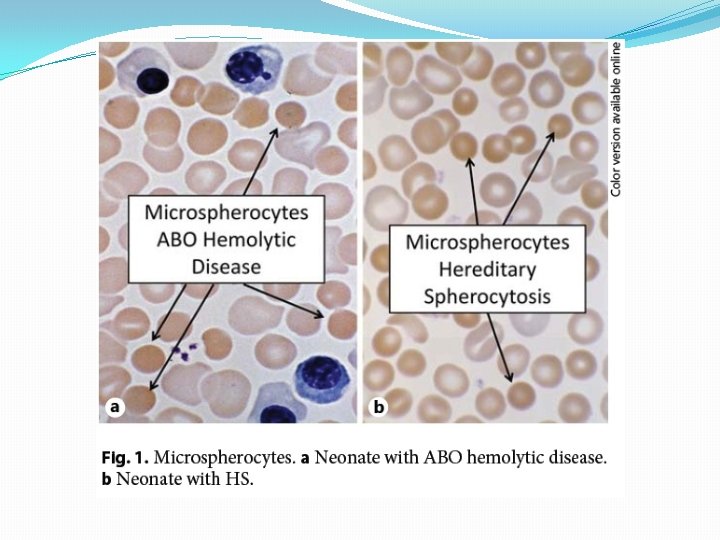
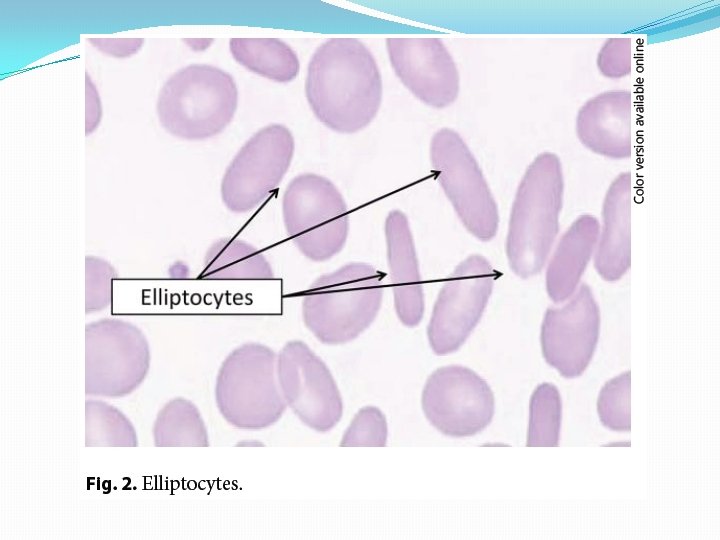

Neonatal Hemolytic Jaundice Hyperbilirubinemia severe jaundice is the


Neonatal Hemolytic Jaundice

�Hyperbilirubinemia ( severe jaundice ) is the most common condition requiring re-hospitalization during the first week of life. �Total Serum Bil (TSB) > 17 mg/dl ≈ 10% �Total Serum Bil (TSB) > 20 mg/dl ≈ 1. 5%

�Most neonates with extreme hyperbilirubinemia have no underlying etiology. � 55% to 66% of neonates with a TSB >30 mg/dl have no etiology (idiopathic jaundice), according to 2 studies.

�Hyperbilirubinemia = bilirubin production bilirubin elimination �Low activity of UGT 1 A 1 ≈ 1% in newborns (diminished conjugation in all newborns) �Prodominant factor in severe jaundice is increased bilirubin production (hemolysis)

Why hemolytic jaundice is important? Increased risk of neurotoxicity

Hemolytic jaundice is likely when: �jaundice observed in first 24 hours �pre-discharge Bil in high risk zone �rising Bil more than 0. 5 mg/dl/h �cord Bil more than 4 mg/dl �prolonged hyperbilirubinemia �low hemoglobin ( < 13 g/dl) �positive direct anti-globulin test (DAT) �Elevated reticulocyte count

Hemolytic jaundice is likely when: � hepatosplenomegaly �finding hemoglobin without erythrocytes in urine �pink serum on a visual examination of a blood sample �absence of haptoglobin in the serum


ABO hemolytic disease �Indirect hyperbilirubinemia during the first 24 h of life �Mother with blood group O, infant with blood group A or B �Spherocytosis on blood smear �Increased reticulocyte count �Evidence of hemolysis based on increased endogenous production of CO �Direct or indirect coombs positive

Incompatibility to other RBC antigens �Anti -c �Anti -E �Anti-Kell





Five diagnostic tests or approaches useful in hemolytic jaundice �Erythrocyte morphology �End-tidal carbon monoxide (ETCO) measurement �EMA flow cytometry for HS and other membrane defects �NGS (Next Generation Sequencing) of relevant genes �An algorythm in judicious use of standard tests

Prediction of Hemolytic Jaundice �Cord bilirubin �Clincal risk factors �Hour-specific bilirubin nomogram

Hour-specific Bilirubin Nomogram

Treatment �Phototherapy �Exchange transfusion �IVIG

Guidelines for Exchange Transfusion
- Slides: 32